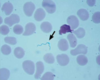

Microbiology-Ulcerative STDs Flashcards
What will the lab say if you ask for a syphilis culture?
Did you ever go to medical school? You can’t culture syphilis.
What bacteria causes chancroid?
Haemophilus ducreyi
A patient presents with a ragged genital ulcer with marked swelling and tenderness. Inguinal lymph nodes are enlarged and tender. What are you looking for in the lab if you suspect chancroid?

Gram negative small rods that require X and V in warm chocolate agar w/10% CO2 to grow. This is characteristic of all haemophilus bacterium. Herpes culture and syphilis antibody tests will be negative.
What differentiates chancroid from syphilis?
Chancroid has painful ulcerations and painful lymphadenopathy.
Organisms that are spiral-shaped, have corkscrew motility, don’t gram stain and grow slowly or not at all in vitro.

Spirochetes. Note that it is a gram-negative organism despite not having LPS.
What are the pathogenic spirochetes?
Treponema (pallidium + carateum): morphologically identical, same serologic response in humans and susceptible to penicillin. Borrelia and Leptospira are zoonotic infections.
What methods can be used to visualize microbial infection causing syphilis?
Treponemes are too thin to see microscopically. They can be visualized by dark field microscopy, direct fluorescent Ab to T. pallidum or silver staining.

Visualization of borrelia spirochetes
Giemsa or Wright stain
Visualization of leptospires
Darkfield microscopy or silver stain

How can syphilis be transmitted?
Sexually and in utero
Greatest source of syphilis
MSM
Why is T. pallidum so infectious?
The 50% infectious dose for humans is < 100 organisms. They infect mucous membranes easily especially if there are small cuts or abrasions.
Why is T. pallidum infection a risk factor for HIV?
Ulcerations allow for easier transmission of HIV
Primary syphilis lesions
Chancre: PAINLESS ulcer with a clean hard base that develops within 2-10 weeks at the primary site of infection. It heals spontaneously but systemic infection persists asymptomatically.
Secondary syphilis lesions
Appear 2-10 weeks after disappearance of chancre: papulosquamous rash on palms/soles, mucous patches on mouth and warty genital lesions (condylomata kata). These resolve and infection continues asymptomatically.
Latent syphilis
Early latency = < 1 year. Late latency = > 1 year.
Tertiary syphilis
1/3 of patient will develop aortitis, neurosyphilis, meningovascular syphilis, tabes dorsalis, general paresis, optic atrophy and late benign syphilis years after infection.

Easy routine tests for syphilis
Non-trepnemal tests. Measures the anti-phospholipid respond (anti-cardiolipin) which are not specific to the organism. Note that other diseases like lupus and malaria can cause a positive test. This is more of a screening test.

Treponemal tests for syphilis
Serum absorbs anti-treponemal antibody specific for t. pallidum.

Drug of choice for T. pallidum
Penicillin G
In pregnancy the risk of transmission to the fetus is highest during which stages of syphilis?
Primary and secondary stages. This is when bacteremia is most likely to occur and crossing of the placenta is a high risk.


